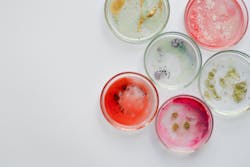
Dreamstime Xxl 178804432 639b2c96089ef Dreamstime Xxl 178804432 639b2c96089ef

New blood test can detect ‘toxic’ protein years before Alzheimer’s symptoms emerge, study shows
However, SOBA did detect oligomers in the blood of 11 individuals from the control group. Follow-up examination records were available for 10 of these individuals, and all were diagnosed years later with mild cognitive impairment or brain pathology consistent with Alzheimer’s disease. Essentially, for these 10 individuals, SOBA had detected the toxic oligomers before symptoms surfaced.
SOBA, which stands for soluble oligomer binding assay, exploits a unique property of the toxic oligomers. When misfolded amyloid beta proteins begin to clump into oligomers, they form a structure known as an alpha sheet. Alpha sheets are not ordinarily found in nature, and past research by Daggett’s team showed that alpha sheets tend to bind to other alpha sheets. At the heart of SOBA is a synthetic alpha sheet designed by her team that can bind to oligomers in samples of either cerebrospinal fluid or blood. The test then uses standard methods to confirm that the oligomers attached to the test surface are made up of amyloid beta proteins.
The team tested SOBA on blood samples from 310 research subjects who had previously made their blood samples and some of their medical records available for Alzheimer’s research. At the time the blood samples had been taken, the subjects were recorded as having no signs of cognitive impairment, mild cognitive impairment, Alzheimer’s disease, or another form of dementia.
SOBA detected oligomers in the blood of individuals with mild cognitive impairment and moderate to severe Alzheimer’s. In 53 cases, the research subject’s diagnosis of Alzheimer’s was verified after death by autopsy — and the blood samples of 52 of them, which had been taken years before their deaths, contained toxic oligomers.
SOBA also detected oligomers in those members of the control group who, records show, later developed mild cognitive impairment. Blood samples from other individuals in the control group who remained unimpaired lacked toxic oligomers.
FDA approves drug that can delay onset of type 1 diabetes
The U.S. Food and Drug Administration approved Tzield (teplizumab-mzwv) injection to delay the onset of stage 3 type 1 diabetes in adults and pediatric patients 8 years and older who currently have stage 2 type 1 diabetes.
Tzield binds to certain immune system cells and delays progression to stage 3 type 1 diabetes. Tzield may deactivate the immune cells that attack insulin-producing cells, while increasing the proportion of cells that help moderate the immune response. Tzield is administered by intravenous infusion once daily for 14 consecutive days.
Tzield’s safety and efficacy were evaluated in a randomized, double-blind, event-driven, placebo-controlled trial with 76 patients with stage 2 type 1 diabetes.
The most common side effects of Tzield include decreased levels of certain white blood cells, rash and headache. The use of Tzield comes with warnings and precautions, including premedicating and monitoring for symptoms of Cytokine Release Syndrome; risk of serious infections; decreased levels of a type of white blood cell called lymphocytes; risk of hypersensitivity reactions; the need to administer all age-appropriate vaccinations prior to starting Tzield; as well as avoiding concurrent use of live, inactivated and mRNA vaccines with Tzield.
New research shows indoor tanning can increase melanoma risk
A new article published in the Journal of the American Academy of Dermatology suggests that indoor tanning is the most frequent cause of multiple primary melanomas, which is when a patient develops additional melanomas after their first one.
In fact, the research showed that melanoma patients with who use tanning beds more than 10 times have nearly double the risk of having a second or multiple melanomas.
This research adds to the growing body of research on the dangers of indoor tanning, including:
- Indoor tanning equipment emits harmful UVA and UVB radiation. The amount of radiation produced during indoor tanning is similar to that of the sun, and in some cases might be stronger.
- Using tanning beds before age 20 can increase your chances of developing melanoma by 47%, and the risk increases with each use.
COVID-19 vaccine’s effectiveness diminishes with age, UTSW research shows
The Pfizer-BioNTech COVID-19 vaccine limits transmission, hospitalization, and death from COVID-19 even among patients infected by variants of the virus, but the effectiveness of antibodies it generates diminishes as patients get older, according to a study by UT Southwestern researchers.
The emergence of new variants, including Delta and Omicron, left the vaccine less effective at neutralizing SARS-CoV-2 and resulted in increased rates of infection. However, vaccinated individuals, even when infected with COVID-19, continued to be protected against severe disease and death.
To understand how vaccines protect people without completely neutralizing the virus, blood samples were analyzed from 51 adults, ranging in age from 21 to 82, who had not been infected previously with COVID-19 and who each received two doses of the Pfizer-BioNTech vaccine between December 2020 and February 2021. From the samples, the researchers isolated antibodies specific to the SARS-CoV-2 spike protein.
The team showed that the antibodies generated in response to the vaccine were effective at neutralizing the original version of SARS-CoV-2 that emerged in 2019 but, as expected, were not as effective against the Delta and Omicron variants. In addition, the researchers found that these antibodies led to the activation of immune cells that can carry out a variety of antiviral effector functions after infection.
These antibody activities and functions differed by age, with people under 65 carrying significantly more of the activities and functions compared to those over 65. Dr. Lu’s team discovered these observations could be attributed to different sugars attached to the antibodies. With age, these sugars change and antibody functions diminish.